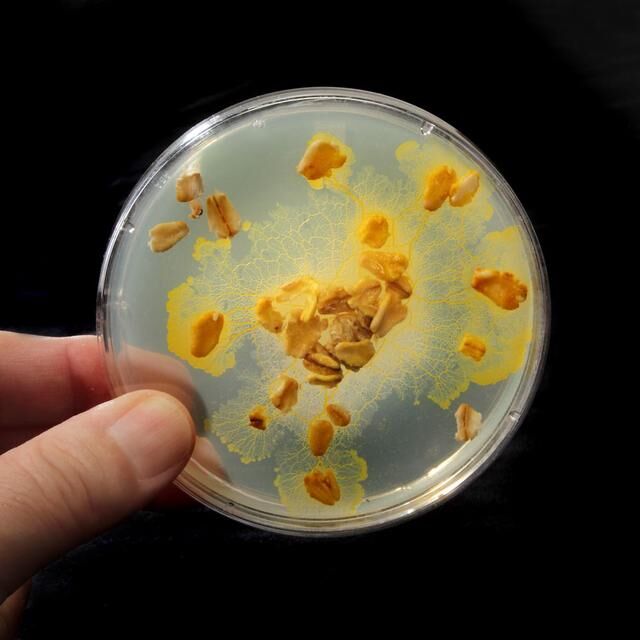
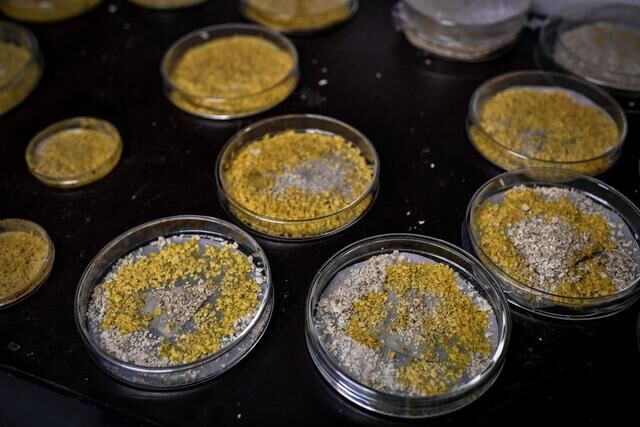

地球上的生物可以说非常的多,但是一般说到生物要么是动物,要么是植物或者是真菌之类的,当然,也存在着一些非常奇特的生物,这些生物并不属于这些类型。像是在巴黎的动物园里面就存在着一种这样的生物,它的表面看起来是那种亮黄色的,非常的漂亮,但是这种并不是植物,也不是动物,更不属于真菌的范围,甚至这种生活都根本没有雌性跟雄性的区别,但是它又存在着多达700多种的性别,这一奇怪生物的出现可以说引起了人们极大的好奇。

据科学家介绍,这种生物其实是属于单细胞生物,而且它的存活时间非常的长,从它出现到现在,最起码已经经历了10亿年的历史。最初发现这种生物的是在1973年,当时在德克萨斯州有一名女性发现了它的存在,当时虽然说新闻也进行了相关的报道,但是随后很快就死掉了,人们也逐步的遗忘了这种生物的存在。

到2016年这种奇怪的生物再次走进了人们的视线中,现在这种生物已经被收藏在了巴黎动物医院,看起来它就像是水母一般的存在,但其实它并不是从外表上来说就像是一堆古老的黄色线条,但是这种线条又会不断的延伸,甚至每个小时能够向前延伸4厘米左右,这个速度是相当惊人的。而且这种奇怪的生物根本就没有大脑,但是它们又能够解决各种复杂的问题,甚至直接将其切成两半都能够重新的再愈合到一起,这种超强的自愈能力也是让人感觉不可思议。
生物科学家称这种奇怪的生物称Physarum polycephalum(多头绒泡菌),很多人也称它为斑点,关于这种生物究竟是属于什么类型,这让科学家非常的困惑,因为它虽然像是真菌,但是它却跟动物一般能够在不同的地方移动,而且它又没有大脑,如果有它感兴趣的食物,那么它能够在极短的时间内学习,并且走出复杂的迷宫。后来专家将其归类为原生生物的一种(这个标签适用于我们所不了解的一切微小生物)
这种单细胞的生物是一种黄色的粘液霉菌,其实现在在世界很多不同的地方都能够看到它们的影子,它们喜欢吃一些真菌、细菌。不过在实验室里面,科学家通过实验发现,这种奇怪的生物对燕麦片可以说非常的感兴趣,燕麦片是它们特别喜欢吃的一种食物,由于想要获得燕麦片,这种生物甚至能够释放出特别怪异的生长潜力。
为了能够捕获到自己所喜欢的食物,它们会不断延伸自己的静脉,而这种延伸的速率可以说是相当惊人的,即便是在有障碍物复杂的迷宫之中,它们也能够快速的去完成,寻找到自己的食物,甚至在找到食物之后,还能够按照自己的原先路线在返回到原先的地方。
通过这样的行为可以发现这种没有脑的生物其实是具有空间记忆能力的,甚至还能够具有分析解决问题的能力,在寻找食物过程中,它们可以寻找到最有效最快速的路径。科学家认为它们是通过一种蜂巢的思维来做出相关的决定的,这对于没有脑细胞的生物来说这样的结构真的是很令人惊讶。

另外还有这种生物的交配繁殖也是吸引了研究学者的关注,这种粘性霉菌究竟是属于雌性还是雄性的,存在着太多的变数,因为它们的性别超过了720种。按照正常来说,性别一般是交配的精子和染色体组合之后决定的,这对于这种黏性霉菌来说情况好像就变得有点复杂了,因为它们并不是简单的两个类型的性染色体,它们是有染色体的三个不同位置来决定的,而且在每个位置上又有很多不同的等位基因。这方面的研究专家对其进行了仔细的研究和统计,结果发现这种粘液霉菌最起码具有720种不同的性染色体组合的可能性,所以它们的性别过于的复杂。
还有关于它们的生命力问题,据研究学者发布的报告指出,这种生物几乎是可以永生的,当然也存在着天敌,那就是光以及过度的干旱。但是当它们在遭受剧烈威胁的时候,它们并不会直接死亡,反而会进行冬眠,而冬眠的时间甚至能够长达几年,看样子想要消灭这种生物,还真的是不容易。





























